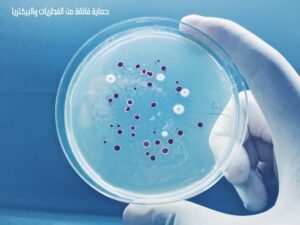
كرافت مكيف اسبليت

او جنرال مكيف مخفي 48000 وحدة بارد ARSG48CMTAZ
10,225 ر.س السعر الأصلي هو: 10,225 ر.س.8,929 ر.سالسعر الحالي هو: 8,929 ر.س.

كرافت مكيف سبلت 17800 وحدة وطني - بارد DSA20CE6YHA1
1,938 ر.س السعر الأصلي هو: 1,938 ر.س.1,694 ر.سالسعر الحالي هو: 1,694 ر.س.


كرافت مكيف اسبليت 11500 وحدة وطني – حار/بارد Dsa12fe7yha1/dsa12ce7yha1
1,797 ر.س السعر الأصلي هو: 1,797 ر.س.1,571 ر.سالسعر الحالي هو: 1,571 ر.س.
| الصنف | كرافت مكيف اسبليت 11500 وحدة وطني – حار/بارد |
|---|---|
| العلامة التجارية | كرافت |
| الموديل | Dsa12fe7yha1/dsa12ce7yha1 |
| اللون | أبيض |
| النوع | مكيف سبليت |
| حجم المكيف | 12000 وحدة |
| قدرة التبريد الفعلية | 11500 وحدة |
| تصنيف الهواء | حار وبارد |
| اتجاه الهواء | رباعى الاتجاهات |
| نوع الضاغط | روتاري |
| نوع التحكم | ريموت كنترول |
| فئة كفاءة الطاقة | D |
| الجهد الكهربائي | 220 – 240 فولت |
| التردد | 50 – 60 هرتز |
| بلد المنشأ | المملكة العربية السعودية |
| الضمان الشامل | عامين |
| الضمان الضاغط | 5 سنوات |
| التصنيف | مكيفات |
غير متوفر في المخزون
رمز المنتج:
Dsa12fe7yha1/dsa12ce7yha1
التصنيفات: المكيفات, سبليت
الوسوم: مكيف 11500 وحدة, مكيف اسبليت, مكيف كرافت
الوصف
كرافت مكيف اسبليت 11500 وحدة وطني – حار/بارد Dsa12fe7yha1/dsa12ce7yha1

تصميم عصري وجميل
يتميز كرافت مكيف اسبليت بتصميمه الأنيق الذي يتناسب مع أي ديكور داخلي. يمكن تركيبه بسهولة في أي غرفة دون أن يؤثر على جمالية المكان.
تكنولوجيا الهواء النقي
يعمل كرافت مكيف اسبليت على تنقية الهواء من الشوائب والروائح، مما يساعد في تحسين جودة الهواء داخل الغرف ويحسن صحة المستخدمين.

قوة التحمل في الأجواء الحارة
يعمل مكيف كرافت بكفاءة عالية في الأجواء الحارة، حيث يقوم بتوفير تبريد فعال حتى في درجات الحرارة المرتفعة، مما يجعله مثاليًا للمناطق ذات الحرارة الشديدة.
معلومات إضافية
- نظام التشغيل : حار/بارد
- القدرة الاسمية : 1 طن
- القدرة الفعلية للتبريد : 11500 وحدة
- نوع الضاغط : روتاري
- كفاءة تشغيل عالية واداء مميز
- يحتوي المكيف على جهاز التحكم عن بعد
- ضاغط روتاري عالي الكفاءة
- توزيع مثالي للهواء في جميع الاتجاهات
- صوت هادىء عند التشغيل فلا يوجد ازعاج
- موفر فى استهلاك الطاقة
- القدرة على التبريد والتدفئة بكفاءة
- فلتر مميز للتخلص من الاتربة والجسيمات الضارة
- تصميم أنيق ومميز يناسب جميع الديكورات
- سهولة الفك والتركيب والصيانة
- بلد المنشأ : المملكة العربية السعودية
- الضمان الشامل : عامين
- أبعاد الوحدة الداخلية للجهاز : 90 * 30 * 21.4 سم
- أيعاد الوحدة الخارجية للجهاز : 81 * 58.5 *28 سم
مراجعات (0)
كن أول من يقيم “كرافت مكيف اسبليت 11500 وحدة وطني – حار/بارد Dsa12fe7yha1/dsa12ce7yha1” إلغاء الرد













المراجعات
لا توجد مراجعات بعد.